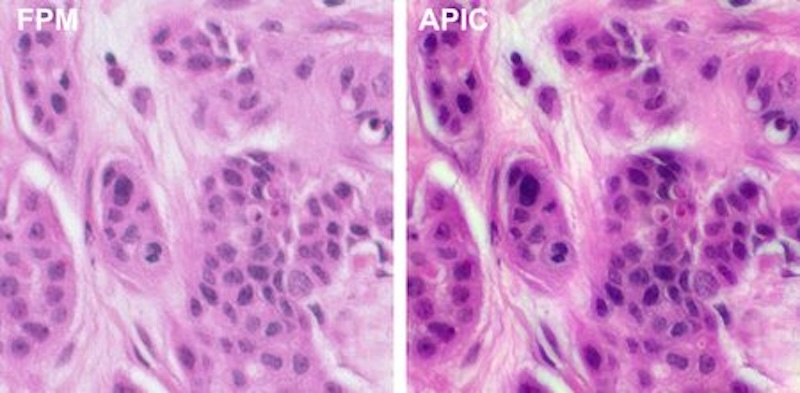
Cancer cells: FPM vs APIC

| A stained breast cancer sample was imaged using red, green, and blue LEDs. Caltech's APIC was used to reconstruct the detailed color image shown on the right. The image shows even higher resolution than the image on the left, which was obtained using FPM. Credit: Caltech. |
| © 2026 SPIE Europe |
|